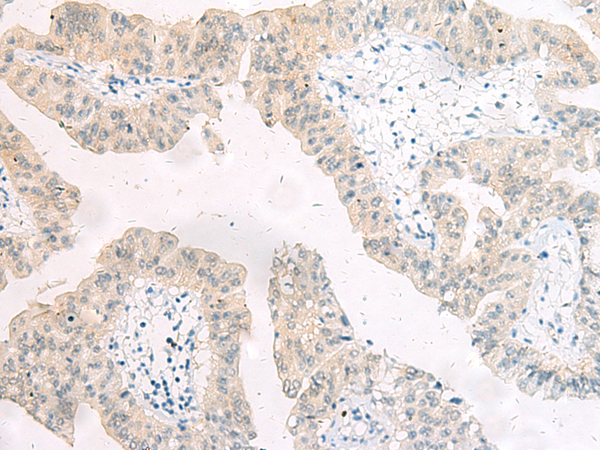

中文名稱:兔抗ARRB1多克隆抗體
|
Background: |
Members of arrestin/beta-arrestin protein family are thought to participate in agonist-mediated desensitization of G-protein-coupled receptors and cause specific dampening of cellular responses to stimuli such as hormones, neurotransmitters, or sensory signals. Arrestin beta 1 is a cytosolic protein and acts as a cofactor in the beta-adrenergic receptor kinase (BARK) mediated desensitization of beta-adrenergic receptors. Besides the central nervous system, it is expressed at high levels in peripheral blood leukocytes, and thus the BARK/beta-arrestin system is believed to play a major role in regulating receptor-mediated immune functions. Alternatively spliced transcripts encoding different isoforms of arrestin beta 1 have been described. |
|
Applications: |
ELISA, IHC |
|
Name of antibody: |
ARRB1 |
|
Immunogen: |
Fusion protein of human ARRB1 |
|
Full name: |
arrestin, beta 1 |
|
Synonyms: |
ARB1; ARR1 |
|
SwissProt: |
P49407 |
|
ELISA Recommended dilution: |
1000-5000 |
|
IHC positive control: |
Human liver cancer and human cervical cancer |
|
IHC Recommend dilution: |
50-200 |
購物車
購物車 幫助
幫助
 021-54845833/15800441009
021-54845833/15800441009
